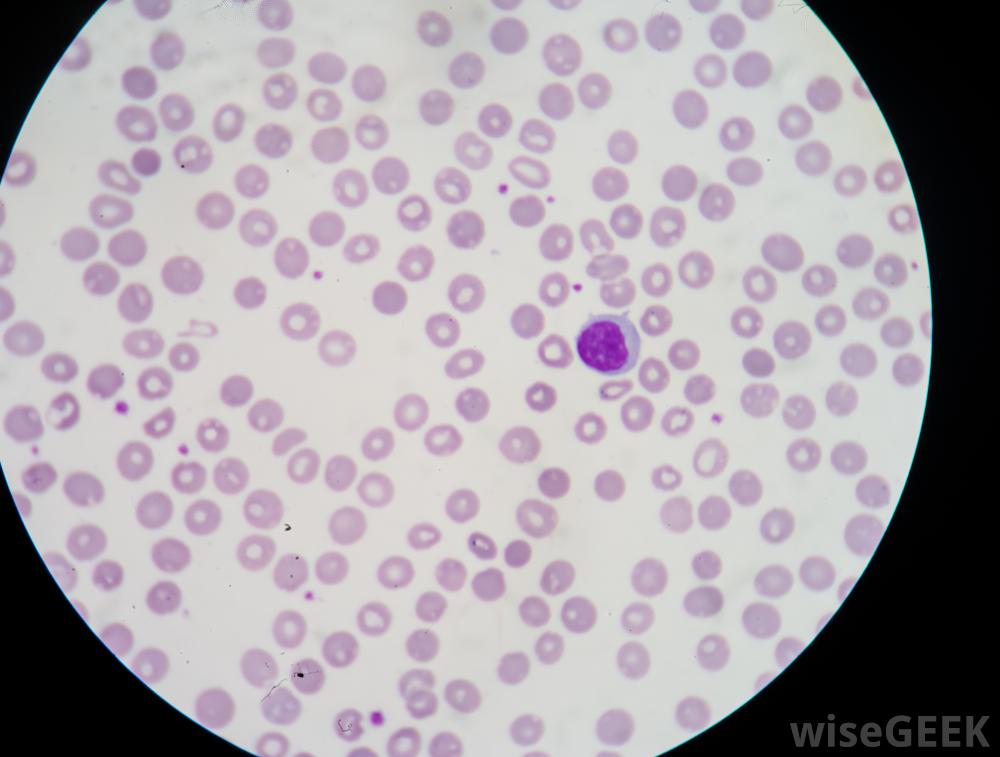

万古霉素是一种能杀死多种细菌病原体的抗生素。这种药物的一个可能的副作用是一系列称为雷德曼综合征的症状,这是由于抗生素干扰免疫系统细胞而发生的过敏反应。 万古霉素和雷德曼综合征的症状可能包括头痛。 由于许多...
万古霉素是一种能杀死多种细菌病原体的抗生素。这种药物的一个可能的副作用是一系列称为雷德曼综合征的症状,这是由于抗生素干扰免疫系统细胞而发生的过敏反应。

万古霉素和雷德曼综合征的症状可能包括头痛。
由于许多严重感染尚未对万古霉素产生耐药性,因此该药通常对细菌感染患者有用,这些细菌感染对其他药物有抗药性。然而,万古霉素可能有两种主要的免疫系统副作用。更严重的是过敏反应,由于面部和喉咙组织肿胀,会导致呼吸困难。如果是万古霉素和雷德曼综合征,症状可能较轻,不会危及生命。

患有万古霉素和雷德曼综合征的人可能会出现血压下降。
万古霉素和雷德曼会出现问题当医生将抗生素注入病人静脉时的综合征。万古霉素和雷德曼综合征的症状在皮肤上最明显。会出现红色和发痒的皮疹,但这与皮肤的轻微发红一样微不足道。头晕,流感样的发烧和头痛也会发生。一些患有万古霉素和雷德曼综合征的人也会出现血压下降或胸痛。

过敏反应可能导致呼吸喉咙组织肿大引起的困难
免疫系统的某些成分导致这些症状。肥大细胞和嗜碱性粒细胞含有一种叫做组胺的物质的储存颗粒。组胺是免疫系统的信号分子之一,万古霉素作用于这些细胞释放储存在细胞内的组胺。

万古霉素可用于治疗结肠炎肠道。
血液循环中组胺水平异常高会导致与雷德曼综合征相关的症状。皮疹和瘙痒是免疫系统不必要的激活。实际上,医生可能会在万古霉素治疗之前给患者服用抗组胺药,以达到预期的免疫效果系统激活。

服用万古霉素的风险可能包括肝损伤。
只有一些人会出现雷德曼综合征,而其他人则不然。科学家认为这是由于个体患者之间的遗传差异。例如,人体内的某些酶会自然分解组胺。有两种酶起作用,分别是组胺N-甲基转酶和二胺氧化酶。不同的人产生的这些酶的版本略有不同,即可能会有不同的效率,这可能是某些人没有雷德曼综合征而另一些人却发展为雷德曼综合征的一个解释。

服用抗生素后出现过敏反应症状的人需要立即就医。
除了潜在的遗传原因外,其他抗生素也可以与万古霉素联合使用,增加患雷德曼综合征的风险这些抗生素的例子,医生可以与万古霉素一起使用,包括环丙沙星和两性霉素。某些止痛药和放松肌肉的药物也会使该综合征更容易发生。
嗜碱性粒细胞,它们会在血液涂片上染上深紫色,含有可能因万古霉素而释放的组胺。